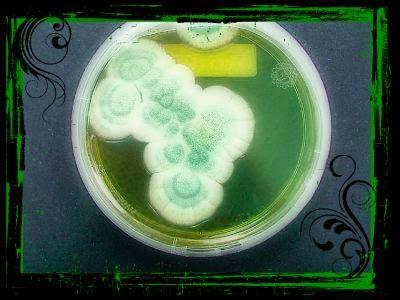
28 Settembre: Penicillin 28 Settembre: Penicillin

Il Giorno: il 28 Settembre 1928 il biologo Alexander Fleming scopre la penicillina. Da quel momento in poi milioni di vite saranno salvate da questo potente antibatterico.La Canzone: in Penicillin Martin Grech ripete costantemente il nome del prezioso farmaco ma questi purtroppo non può rinsaldare i rapporti familiari.
